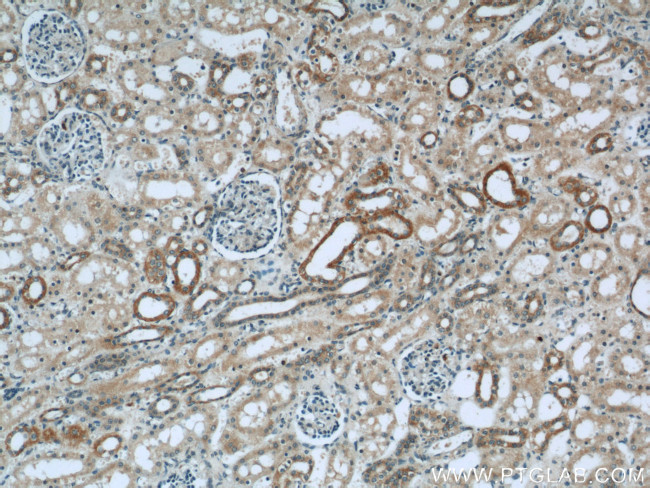
OXER1 Antibody in Immunohistochemistry (Paraffin) (IHC (P))
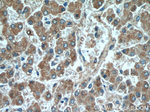
OXER1 Antibody in Immunohistochemistry (Paraffin) (IHC (P))

Search
Proteintech
OXER1 Polyclonal Antibody
{{$productOrderCtrl.translations['antibody.pdp.commerceCard.promotion.promotions']}}
{{$productOrderCtrl.translations['antibody.pdp.commerceCard.promotion.viewpromo']}}
{{$productOrderCtrl.translations['antibody.pdp.commerceCard.promotion.promocode']}}: {{promo.promoCode}} {{promo.promoTitle}} {{promo.promoDescription}}. {{$productOrderCtrl.translations['antibody.pdp.commerceCard.promotion.learnmore']}}
产品信息
55202-1-AP
种属反应
宿主/亚型
分类
类型
抗原
偶联物
形式
浓度
规格
纯化类型
保存液
内含物
保存条件
运输条件
产品详细信息
This antibody is specific to OXER1.
靶标信息
TG1019 is a G protein-coupled receptor that functions as a chemoattractant for eosinophils and neutrophils. TG1019 is expressed in various tissues except the brain, with the highest expression in liver, kidney, peripheral leukocyte, lung and spleen. TG1019 interacts with the protein OXE to form TG1019/OXE, a Galpha i/o protein-coupled receptor. Signals from TG1019 are transduced via a Galpha i/o protein to PLC/calcium, MEK/ERK and PI3K/Akt pathways. Signal transduction from TG1019 following stimulation with 5-oxo-6E,8Z,11Z,14Z eicosatetraenoic acid (5-oxo-ETE) induces intracellular calcium mobilization and rapid activation of MEK/ERK and PI3K/Akt pathways. TG1019 also may play a role in downregulating cAMP production.
仅用于科研。不用于诊断过程。未经明确授权不得转售。
篇参考文献 (0)
生物信息学
蛋白别名: 5-oxo-ETE acid G-protein-coupled receptor 1; 5-oxo-ETE G-protein coupled receptor; G-protein coupled receptor 170; G-protein coupled receptor R527; G-protein coupled receptor TG1019; GPCR; HEOAD54; OXE receptor; oxoeicosanoid (OXE) receptor 1; Oxoeicosanoid receptor 1
基因别名: GPCR; GPR170; OXER1; TG1019
UniProt ID: (Human) Q8TDS5
Entrez Gene ID: (Human) 165140